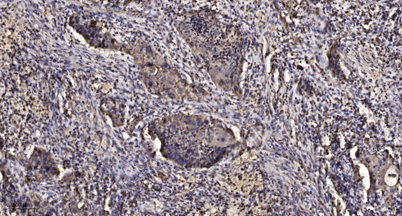

MCM3 (phospho-Ser112) rabbit pAb
 One-click to copy product information
One-click to copy product information$148.00/50µL $248.00/100µL
| 50 µL | $148.00 |
| 100 µL | $248.00 |
Overview
| Product name: | MCM3 (phospho-Ser112) rabbit pAb |
| Reactivity: | Human;Rat;Mouse; |
| Alternative Names: | DNA replication licensing factor MCM3 (EC 3.6.4.12) (DNA polymerase alpha holoenzyme-associated protein P1) (P1-MCM3) (RLF subunit beta) (p102) |
| Source: | Rabbit |
| Dilutions: | WB 1:500-2000;IHC-p 1:50-300; ELISA 2000-20000 |
| Immunogen: | Synthesized phosho peptide around human MCM3 (Ser112) |
| Storage: | -20°C/1 year |
| Clonality: | Polyclonal |
| Isotype: | IgG |
| Concentration: | 1 mg/ml |
| Observed Band: | 89kD |
| GeneID: | 4172 |
| Human Swiss-Prot No: | P25205 |
| Cellular localization: | Nucleus . Chromosome . Associated with chromatin before the formation of nuclei and detaches from it as DNA replication progresses. . |
| Background: | The protein encoded by this gene is one of the highly conserved mini-chromosome maintenance proteins (MCM) that are involved in the initiation of eukaryotic genome replication. The hexameric protein complex formed by MCM proteins is a key component of the pre-replication complex (pre_RC) and may be involved in the formation of replication forks and in the recruitment of other DNA replication related proteins. This protein is a subunit of the protein complex that consists of MCM2-7. It has been shown to interact directly with MCM5/CDC46. This protein also interacts with and is acetylated by MCM3AP, a chromatin-associated acetyltransferase. The acetylation of this protein inhibits the initiation of DNA replication and cell cycle progression. Two transcript variants encoding different isoforms have been found for this gene. [provided by RefSeq, Jul 2012], |

 Manual
Manual